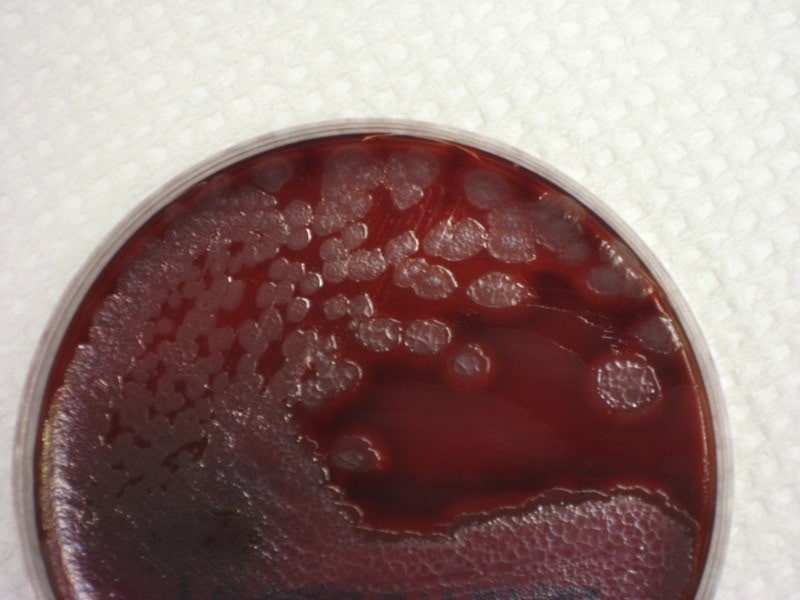
s/تشخیص سودوموناس در محصولات پزشکی

تشخیص سودوموناس در محصولات پزشکی؛ عفونت سودوموناس چیست؟ علل، علائم، تشخیص و درمان
عفونت سودوموناس عفونتی است که توسط باکتری های گروه سودوموناس به عنوان یکی از پاتوژن های فرصت طلب ایجاد می شود. آنها می توانند با ایجاد عفونت در بسیاری از قسمت های بدن باعث بیماری های مختلفی شوند.
باکتری سودوموناس با آنتی بیوتیک درمان می شود. درمان با تشخیص سریع آسان تر است. در این مقاله می توانید متوجه شوید که عفونت سودوموناس چیست، علائم، درمان و راه های پیشگیری از آن چیست.

برای کسب اطلاعات بیشتر و دریافت خدمات با ما تماس بگیرید.
عفونت سودوموناس (پسودوموناس) چیست؟
عفونت های سودوموناس بیماری های عفونی ناشی از باکتری های جنس سودوموناس هستند. این باکتری ها در آب، خاک و محیط زیست رایج هستند.
باکتری های گروه سودوموناس معمولاً در افراد سالم باعث عفونت نمی شوند. عفونت سودوموناس که در افراد سالم رخ می دهد، سیر خفیفی دارد.
باکتری هایی به نام سودوموناس پاتوژن های نسبتاً رایجی هستند که در عفونت بیمارستانی دخیل هستند. این یکی از عوامل مهم عفونت های بیمارستانی است و می تواند باعث بیماری شود.
این می تواند باعث عفونت های جدی در افرادی شود که بیماری دیگری دارند، به دلیل شرایط مختلف در بیمارستان بستری هستند یا سیستم ایمنی ضعیفی دارند.
عفونت سودوموناس می تواند در هر قسمتی از بدن ایجاد شود. علائمی که رخ خواهند داد بستگی به این دارد که کدام قسمت از بدن آلوده شده است. عفونت سودوموناس با آنتی بیوتیک های موجود درمان می شود. عفونت درمان نشده یا پیشرونده می تواند کشنده باشد.
چه چیزی باعث عفونت سودوموناس می شود؟
عفونت سودوموناس توسط باکتری هایی از جنس سودوموناس ایجاد می شود. این باکتری ها در مناطق مرطوب زندگی می کنند. آنها معمولا در خاک و آب یافت می شوند.
باکتری های زیادی متعلق به جنس سودوموناس هستند. برخی از اینها باعث عفونت در انسان می شوند. شایع ترین نوع ایجاد عفونت سودوموناس آئروژینوزا است.
چه کسانی در معرض خطر عفونت سودوموناس هستند؟
افراد سالم عمدتاً در معرض خطر کم عفونت هستند. عفونت در افرادی که سیستم ایمنی ضعیفی دارند، معمولاً به دلیل بیماری یا شرایط دیگری رخ می دهد. بیمارانی که برای مدت طولانی در بیمارستان بستری هستند به ویژه در معرض خطر هستند.
عفونت سودوموناس عفونت فرصت طلبی هم در نظر گرفته می شود. عفونتهای فرصتطلب به این معنی است که اگر سیستم ایمنی بدن فرد به خطر بیفتد، میتوانند باعث بیماری شوند.
تشخیص سودوموناس
CSIC یک تکنیک ایمونوشیمیایی را برای تشخیص عفونتهای ناشی از سودوموناس آئروژینوزا با شناسایی مولکولهای سیگنالدهنده اصلی که این باکتریها برای برقراری ارتباط استفاده میکنند (Quorum Sensing) توسعه داده است. این تست بسیار خاص است و حساسیت بالایی دارد و همچنین ظرفیت پردازش نمونه بالایی دارد که کارایی تشخیصی را تضمین می کند. همچنین می توان آن را به راحتی در دستگاه های نقطه مراقبت (PoC) پیاده سازی کرد.
برای چند سال نسبتاً، تعامل "اجتماعی" بین باکتری ها موضوع مطالعه بوده است. این تعامل به لطف یک سیستم ارتباطی سلولی پیچیده به نام "Quorum Sensing" یا QS امکان پذیر است که به باکتری ها اجازه می دهد اطلاعات مربوط به تراکم جمعیت خود را یاد بگیرند و به اشتراک بگذارند.
در نتیجه، القای جمعی بیان ژنهایی وجود دارد که طیف گستردهای از فعالیتهای فیزیولوژیکی را تنظیم میکنند، از جمله ترشح فاکتورهای حدت یا تشکیل بیوفیلمها، که مستقیماً با توسعه بیماریزایی مرتبط است.
برای برقراری ارتباط از این طریق، باکتریها مولکولهای کوچکی را ترشح کرده و شناسایی میکنند که بهعنوان سیگنالدهنده شیمیایی عمل میکنند و در واقع میتوانند در محیط خارج سلولی که استعمار رخ داده است، شناسایی شوند.
برای برقراری ارتباط با یکدیگر، باکتریها مولکولهای کوچکی را ترشح میکنند که به عنوان سیگنالدهنده شیمیایی عمل میکنند.
- aeruginosa در مخاط بیماران مبتلا به فیبروز کیستیک. این روش قادر است بین مرحله حاد یا مزمن عفونت تمایز قائل شود.
- aeruginosa در مخاط بیماران مبتلا به فیبروز کیستیک. این روش قادر است بین مرحله حاد یا مزمن عفونت تمایز قائل شود.
محققان مؤسسه شیمی پیشرفته کاتالونیا (IQAC) یک سیستم تشخیص برای برخی از مولکولهای سیگنالینگ سنجش حد نصاب P. aeruginosa ایجاد کردهاند که برای تشخیص عفونتهای ناشی از این میکروارگانیسم مفید است. همانطور که آنها توضیح می دهند، رابطه نزدیک بین آزادسازی این مولکول های سیگنال دهنده و بیماری زایش، این مولکول ها را به نشانگرهای زیستی عالی برای تشخیص عفونت تبدیل می کند.
سودوموناس آئروژینوزا یک باکتری محیطی همه جا حاضر با حداقل نیاز برای بقا و توانایی قابل توجه برای سازگاری با محیط است. این بیماری مسئول تعداد زیادی از عفونت ها، به ویژه در بیماران بستری در بیمارستان یا مبتلا به سرکوب سیستم ایمنی است، و می تواند باعث سپسیس (عفونت خون) شود، که در صورت عدم تشخیص و درمان صحیح در مراحل اولیه، می تواند کشنده باشد.
شرایطی که ممکن است خطر عفونت سودوموناس را افزایش دهد عبارتند از:
داشتن سوختگی شدید
تحت عمل جراحی یا یک روش تهاجمی دیگر
با استفاده از دستگاه تنفس یا کاتتر
تحت درمان شیمی درمانی برای سرطان
داشتن فیبروز کیستیک
HIV یا ایدز
داشتن دیابت
بیماری سیستم ایمنی دارند
مصرف داروهای سرکوب کننده سیستم های ایمنی (داروهای سرکوب کننده سیستم ایمنی)
مقالات بیشتر:
تست خون سازگاری و هولیز کنندگی

برای کسب اطلاعات بیشتر و دریافت خدمات با ما تماس بگیرید.
علائم عفونت سودوموناس چیست؟
عفونت سودوموناس می تواند در بسیاری از قسمت های بدن رخ دهد. علائم با توجه به قسمتی از بدن که عفونت در آن قرار دارد شکل می گیرد. علائم ناشی از عفونت سودوموناس عبارتند از:
خون
عفونت باکتریایی خون را مسمومیت خون (باکتریمی) می نامند. عفونت خون یکی از جدی ترین عفونت های ناشی از سودوموناس است. علائمی که رخ می دهد عبارت اند از:
آتش
تکان دادن
خستگی و ضعف
درد عضلات و مفاصل
وجود باکتری سودوموناس در خون می تواند باعث شوک همودینامیک شود. می تواند باعث کاهش فشار خون شود و به اندام هایی مانند قلب، کلیه ها و کبد آسیب برساند.
ریه
عفونت ریه را پنومونی می نامند. باکتری سودوموناس دوست دارد در ریه ها مستقر شود و باعث عفونت ریه شود. علائمی که رخ می دهد عبارت اند از:
تکان دادن
آتش
سرفه با خلط یا بدون خلط
مشکل در تنفس
گوش
باکتری سودوموناس را می توان به وفور در آب یافت. عفونت پس از تماس گوش با آب رخ می دهد. می تواند باعث گوش شناگر شود. علائمی که رخ می دهد عبارت اند از:
پری گوش
گوش درد
خارش گوش
ترشحات گوش
مشکل شنوایی
مژه
گاهی اوقات ممکن است باعث عفونت چشم شود. علائم عفونت چشم عبارتند از:
التهاب
چشم درد
تورم چشم
سرخی
تاری دید
پوست
هنگامی که عفونت سودوموناس روی پوست تأثیر می گذارد، اغلب فولیکول های مو را تحت تأثیر قرار می دهد. علائم روی پوست عبارتند از:
بثورات پوستی
تشکیل آبسه روی پوست
زخم های تخلیه
سایر علائم
علائم دیگری که ممکن است به دلیل عفونت سودوموناس رخ دهد عبارتند از:
سردرد
حالت تهوع، استفراغ
عفونت مجاری ادراری
سفتی مفصل
تب شدید
برای کسب اطلاعات بیشتر و دریافت خدمات با ما تماس بگیرید.
چگونه عفونت سودوموناس تشخیص داده می شود؟
هنگامی که به یک ارائه دهنده مراقبت های بهداشتی مراجعه می کنید، پزشک معاینه فیزیکی انجام می دهد و سابقه پزشکی شما را زیر سوال می برد. او علائم عفونت را ارزیابی می کند و از شما می خواهد چند آزمایش انجام دهید.
آبسه ممکن است نمونه خون، ادرار یا بافت را بگیرد و به آزمایشگاه بفرستد. آزمایشگاه ها با آزمایش نمونه های گرفته شده به تشخیص کمک می کنند. پزشک از شما می پرسد که آیا اخیراً در استخر یا گل بوده اید یا خیر.
عفونت سودوموناس چگونه درمان می شود؟
سودوموناس یک باکتری است و عفونت های باکتریایی با آنتی بیوتیک درمان می شوند. ممکن است برای عفونت سودوموناس به داروهای قوی و رویکرد درمانی تهاجمی نیاز باشد.
هرچه درمان زودتر شروع شود، اثربخشی آن بیشتر خواهد بود. اکثر عفونت ها بدون درمان یا پس از درمان کمی برطرف می شوند.
افزایش مقاومت آنتی بیوتیکی درمان عفونت ها را دشوارتر کرده است. عفونت سودوموناس اغلب می تواند به بیش از یک نوع آنتی بیوتیک مقاومت ایجاد کند.
مهم است که پزشک یک آنتی بیوتیک کاملا موثر را انتخاب کند. برای درمان موثرتر می توان نمونه ای از بیمار را برای آزمایش به آزمایشگاه فرستاد. آزمایشگاه نمونه ها را آزمایش می کند تا مشخص کند کدام آنتی بیوتیک میتواند بهتر عمل می کند.
آنتی بیوتیک هایی که می توانند در عفونت سودوموناس استفاده شوند عبارتند از:
سفتازیدیم
سفپیم من
سیپروفلوکساسین
لووفلوکساسین
آزترئونام
کارباپنم ها
تیکارسیلین
جنتامایسین
درمان آنتی بیوتیکی با توجه به محل عفونت و سطح بیماری تعیین می شود. مراقب باشید که داروی خود را طبق دستور پزشک خود استفاده کنید.
چگونه از عفونت سودوموناس پیشگیری کنیم؟
با توجه به شرایط خاصی می توان از عفونت سودوموناس پیشگیری کرد. این باکتری ها در مکان های مرطوب زندگی می کنند و رشد می کنند. هر چه این نواحی کثیف تر و مرطوب تر باشند، میزبان باکتری های بیشتری هستند. بنابراین در هر کجا که هستید باید به نظافت خود توجه کنید.
برای جلوگیری از عفونت سودوموناس باید به موارد زیر توجه کرد:
در بیمارستان دست های خود را مرتب بشویید و خشک کنید
در زندگی روزمره خود مرتباً دستان خود را بشویید و خشک کنید
از استخرها و سوناهای ناپاک خودداری کنید
از تمیز بودن جکوزی ها اطمینان حاصل کنید
بعد از شنا یک دوش کوتاه با صابون بگیرید
گوش های خود را بعد از شنا کردن خشک کنید
قسمت های پانسمان خود را خشک نگه دارید، زمانی که خیس است تعویض کنید
باکتری سودوموناس به طور کلی بی ضرر است. هنگامی که باعث عفونت می شوند در افراد سالم مشکلات خفیفی ایجاد می کنند.
عفونت سودوموناس در افراد با سیستم ایمنی ضعیف می تواند شدید باشد. افراد در معرض خطر عوارض باید در اسرع وقت به پزشک مراجعه کنند.

برای کسب اطلاعات بیشتر و دریافت خدمات با ما تماس بگیرید.
نژاد سودوموناس آئروژینوزا به چه معناست؟
شناسایی باکتری برای جزئیات بیماری های مختلف تلاش می شود. به همین دلیل کشت مواد مغذی انجام می شود. نمونه های خلط، خون و ادرار گرفته می شود و از نظر رشد باکتری مورد آزمایش قرار می گیرد. اگر باکتری سودوموناس آئروژینوزا در نتیجه مطالعه کشت رشد کند، در گزارشی که در نتیجه کشت ارائه می شود، عبارتی با عنوان "پسودوموناس آئروژینوزا رشد کرده است" نوشته می شود.
تجزیه و تحلیل سودوموناس آئروژینوزا
ما همچنین سودوموناس آئروژینوزا را در محدوده مطالعات تحلیلی که برای انواع محصولات آرایشی انجام می دهیم، تجزیه و تحلیل می کنیم. با گرفتن مقداری از نمونه محصول آرایشی رقیق می شود. سپس این نمونه در دمای ایده آل و برای زمان ایده آل انکوبه می شود. پس از آن، تلقیح بر روی یک محیط انتخابی ویژه برای شناسایی باکتری سودوموناس انجام می شود.
پس از انتظار برای زمان ایده آل، کار آنالیز سودوموناس آئروژینوزا آغاز شده و کلنی های مثبت شناسایی می شوند. نتایج منفی در این تحلیل به عنوان "تشخیص نشده" ثبت می شود و با این بیانیه به گزارش اضافه می شود. برخی از باکتری ها نیز باید در مطالعات آنالیز انجام شده در محدوده دستورالعمل های کنترل میکروبیولوژیکی محصولات آرایشی مورد آزمایش قرار گیرند. تعداد کل باکتری های مزوفیل هوازی، تعداد کپک و مخمر، سودوموناس آئروژینوزا، استافیلوکوکوس اورئوس، اشریشیا کلی و کاندیدا آلبیکنس این باکتری ها هستند.
ما برای خدمات تجزیه و تحلیل سودوموناس آئروژینوزا اینجا هستیم!
همچنین می توانید از این مطالعه آزمایشی برای اثبات و گزارش ایمنی محصولات نهایی بهره مند شوید. ما می توانیم معیارهای محصولات آرایشی نهایی را به شرح زیر لیست کنیم:
در محدوده دسته اول، محصولات تهیه شده برای کودکان زیر 3 سال، محصولات اعمال شده روی چشم و اطراف چشم، محصولات اعمال شده بر روی غشاهای مخاطی و محصولاتی که بدون شستشو استفاده می شوند وجود دارد.
در دسته دوم، محصولات آرایشی و بهداشتی که با آبکشی استفاده می شوند و محصولاتی که در دسته اول نیستند. برای دسته اول، تعداد میکروارگانیسم های زنده نباید از 100 cfu/g یا 100 cfu/ml تجاوز کند. برای دسته دوم، مهم است که تعداد میکروارگانیسم های زنده بیش از 1000 cfu/g یا 1000 cfu/ml نباشد.
در همان زمان، پاتوژن های بالقوه را می توان شناسایی کرد. همچنین می توانید از این خدماتی که ما برای تشخیص باکتری سودوموناس آئروژینوزا، استافیلوکوکوس اورئوس، اشریشیا کلی و کاندیدا آلبیکنس ارائه می دهیم بهره مند شوید. اگر می خواهید اطلاعات دقیق تری در این زمینه کسب کنید، می توانید بلافاصله با ما تماس بگیرید.
سودوموناها باکتری های گرم منفی میله ای شکل و غیر اسپور ساز با تاژک های قطبی هستند. شناخته شده ترین نماینده این گونه Pseudomonas aeruginosa است. این باکتری که در سال 1900 کشف شد، به دلیل مقاومت قوی در برابر آنتی بیوتیک ها، یکی از خطرناک ترین میکروب های بیمارستانی است.
سودوموناها برای متابولیسم انرژی خود به اکسیژن نیاز دارند. در عوض، از نیترات برای تنفس استفاده می کنند. آنها در همه جای محیط وجود دارند و اغلب از مواد آلی مرده تغذیه می کنند. آنها توانایی بسیار خوبی برای سازگاری دارند و با مواد مغذی کمی راضی هستند. آنها در خاک، در آب، روی گیاهان یا حیوانات وجود دارند. آنها می توانند به عنوان پاتوژن های فرصت طلب روی گیاهان یا حیواناتی که قبلا ضعیف شده اند عمل کنند. اما همه آنها اثر بیماری زا ندارند و برخی حتی به محافظت از گیاهان کمک می کنند.
سودوموناس آئروژینوزا: یک میکروب خطرناک به ویژه برای انسان
چه کسی می گوید سودوموناس، اغلب فکر می کند سودوموناس آئروژینوزا، یک باکتری مسئول بسیاری از عفونت های انسانی است که در یک بیوفیلم ادغام شده، مقاومت بالایی در برابر آنتی بیوتیک ها دارد. علائم به جایی که عفونت در بدن ایجاد می شود بستگی دارد. این باکتری همچنین مسئول فساد مواد غذایی است. این ماده قادر است در آب مقطر یا محصولات ضدعفونی کننده خاص زنده بماند و توسعه یابد، به شرطی که حاوی مقدار اندکی از مواد آلی باشند.
سودوموناس آئروژینوزا می تواند باعث عفونت شدید ریه و سپسیس شود. این باکتری از جمله با بیماری های زیر مرتبط است: عفونت های دستگاه ادراری، التهاب گوش میانی، عفونت زخم ها یا دریچه های قلب. در آلمان، این میکروب عامل 10 درصد از عفونت های بیمارستانی است. تخمین زده می شود که 25000 مرگ در اروپا به عفونت های بیمارستانی ناشی از پاتوژن های مقاوم به آنتی بیوتیک نسبت داده شود.
افراد در معرض خطر چه کسانی هستند؟
افرادی که به دلیل بیماری های قبلی ضعیف شده اند، به ویژه در معرض خطر بالای ابتلا به عفونت ناشی از سودومونادها هستند. افراد در معرض خطر مبتلا به دیابت یا فیبروز کیستیک، اما همچنین افراد دارای نقص ایمنی به دلیل عفونت HIV طبقه بندی می شوند. بیماران دچار نقص ایمنی (پس از پیوند عضو یا افراد مبتلا به سرطان) نباید با باکتری تماس داشته باشند. به طور کلی می توان گفت که بیماران بستری در بیمارستان در معرض خطر هستند زیرا سیستم ایمنی آنها برای اکثر آنها حداقل در طول اقامت در محیط بیمارستان ضعیف شده است.
راه انتقال باکتری چیست؟
باکتری ها مناطق مرطوب را ترجیح می دهند: سینک، توالت، استخرهای شنا با کلر ضعیف و لوله های آب گرم، اما همچنین محلول های ضد عفونی کننده تاریخ مصرف گذشته و غیرفعال شده. سودوموناس آئروژینوزا از طریق آب آشامیدنی یا از طریق وسایل پزشکی مانند کاتتر یا ماسک تنفسی منتقل می شود. ایمپلنت ها نیز خطراتی دارند زیرا بیوفیلم حاوی این باکتری ها می تواند روی سطح آنها تشکیل شود. در بیمارستان ها، این میکروب توسط پرسنل پرستاری نیز قابل انتقال است.
محدودیت گسترش
گزارش های داده های مختلف²،³ کاهش شیوع عفونت های بیمارستانی را در سال های اخیر نشان داده اند. این امر به ویژه به دلیل بهبود اقدامات بهداشتی در بیمارستان ها است. اهمیت آب از شبکه های توزیع خانگی به عنوان منبع عفونت در حال حاضر به خوبی مستند شده است. یک استراتژی پیشگیری موثر استفاده از فیلترهای ترمینال یا درون خطی است که به کاهش چشمگیر میزان عفونت ناشی از سودوموناس آئروژینوزا در بیمارستان ها کمک می کند. اقدامات ضدعفونی شیمیایی یا حرارتی نیز بخشی از طرح بهداشتی است. به منظور تضمین استانداردهای با کیفیت بالا در موسسات بیمارستانی، آب ورودی از شبکه خانگی باید حداقل هر شش ماه یکبار مورد بررسی قرار گیرد تا احتمال وجود برخی عوامل بیماری زا مشخص شود. ارتباط نزدیک بین شرکت های تامین آب و بیمارستان ها نیز مهم است، به ویژه پس از بارندگی های شدید که غلظت عوامل بیماری زا در آب افزایش می یابد.
سودوموناها به دلیل مقاومت قوی آنها در برابر آنتی بیوتیک ها هنوز یک خطر واقعی هستند، بنابراین ادامه اجرای اقدامات بهداشتی مناسب در سراسر قلمرو مهم است.
مقالات بیشتر:
تشخیص سالمونلا در محصولات پزشکی
تشخیص اشرشیا کلی در محصولات پزشکی
خلاصه
سودوموناس آئروژینوزا میکروارگانیسمی است که باعث عفونت های حاد یا مزمن، گاهی اوقات جدی و کشنده می شود. این بیماری به ویژه در بیمارستان ها شایع است و بیمارانی را که سیستم ایمنی ضعیفی دارند در معرض دید قرار می دهد. مقاومت رو به رشد سویه های خاصی از این باکتری به آنتی بیوتیک ها این عفونت ها را به یک مشکل واقعی برای سلامت عمومی تبدیل می کند.
هر ساله در فرانسه، 750000 عفونت بیمارستانی (که در طول یا بعد از بستری شدن در بیمارستان ایجاد می شود) ثبت می شود، یعنی 5٪ از کل بیماران، مسئول حدود 4000 مرگ و میر. (1) با توجه به نتایج یک بررسی ملی در مورد شیوع عفونت های بیمارستانی که توسط موسسه نظارت بر سلامت انجام شده است، نسبت این عفونت های قابل انتساب به باکتری سودوموناس آئروژینوزا بیش از 8٪ است. (2)
علائم
سودوموناس آئروژینوزا مسئول عفونت های متعدد در بدن است: ادراری، پوستی، ریوی، چشمی و غیره.
منشاء بیماری
سودوموناس آئروژینوزا یک باکتری گرم منفی است که در خاک، آب و محیط های مرطوب مانند شیرها و لوله ها زندگی می کند و سازگاری بالایی با محیط های خشن دارد. فاکتورهای بیماریزای متعدد آن را به یک عامل بسیار بیماریزا برای ارگانیسم های ضعیف یا نقص ایمنی تبدیل می کند که منجر به نرخ بالایی از عوارض و مرگ و میر می شود.
عوامل خطر
افرادی که در بیمارستان ها بیشتر در معرض خطر هستند، بیماران هستند: کسانی که تحت عمل جراحی قرار گرفته اند. قرار گرفتن در معرض یک دستگاه تهاجمی مانند کاتتر ادراری، کاتتر یا لوله گذاری؛ نقص ایمنی در اثر اچ آی وی یا شیمی درمانی. توجه داشته باشید که افراد جوان و مسن نیز بیشتر در معرض خطر هستند. قربانیان سوختگی بسیار در معرض خطر، اغلب کشنده، عفونت های پوستی هستند. سودوموناس آئروژینوزا تقریباً 40 درصد از مرگ و میرهای مرتبط با پنومونی مرتبط با ونتیلاتور را ایجاد می کند.
انتقال سودوموناس آئروژینوزا از طریق دست کارکنان مراقبت های بهداشتی و از طریق تجهیزات پزشکی آلوده صورت می گیرد. روش های تهاجمی پزشکی مانند قرار دادن کاتتر یا کاتتر ادراری خطر بالایی برای انتقال عوامل عفونی دارد.
در حالی که عفونتها در بیمارستانها بزرگترین چالش بهداشت عمومی را ایجاد میکنند، باید به خاطر داشت که سودوموناس آئروژینوزا در آنجا محدود نمیشود و عفونتها میتوانند در جاهای دیگر رخ دهند، به عنوان مثال در حمامهای آب گرم یا استخرهایی که نگهداری ضعیفی دارند (اغلب از طریق لنزهای تماسی). به طور مشابه، این باکتری ممکن است در عفونت های ناشی از غذا نقش داشته باشد.
پیشگیری و درمان
دست های پرسنل پرستاری و همچنین مواد پزشکی باید قبل و بعد از هر درمان شسته و/یا ضدعفونی و یا استریل شوند، طبق پروتکل های تعیین شده یک سیستم ملی در فرانسه برای جلوگیری از عفونتهای بیمارستانی راهاندازی شده است: کمیتههای مبارزه با عفونتهای بیمارستانی (CLIN) از اجرای اقدامات بهداشتی و آسپپسی شدید در بیمارستانها و احترام آنها توسط کارکنان پرستاری، بازدیدکنندگان و خود بیماران اطمینان میدهند.
از اوایل دهه 2000 پیشرفت هایی حاصل شده است، به عنوان مثال، استفاده از محلول های هیدروالکلی برای بهداشت دست و استفاده از سیلیکون که کمتر برای توسعه باکتری ها در تجهیزات پزشکی مفید است.
درمان آنتی بیوتیکی عفونت های بیمارستانی و عفونت های ناشی از سودوموناس آئروژینوزا باید این واقعیت را در نظر بگیرد که سویه های باکتری نسبت به تعداد فزاینده ای از این آنتی بیوتیک ها مقاومت نشان می دهند. در واقع، تقریباً 20 درصد از سویه های باکتری سودوموناس آئروژینوزا به آنتی بیوتیک های سفتازیدیم و کارباپنم ها مقاوم هستند.
مقالات بیشتر:
بررسی خاصیت ضد میکروبی انواع ضد عفونی کننده های پزشکی
طیف گسترده ای از عفونت ها
این باکتری مسئول طیف گسترده ای از عفونت ها از جمله دستگاه ادراری، دستگاه تنفسی و دستگاه گوارش و درم است. تشخیص سنتی با استفاده از تست های میکروبیولوژیکی ممکن است بین 24 تا 48 ساعت برای تعیین عامل ایجاد کننده عفونت نیاز داشته باشد.
روشهای دیگر، مانند PCR، سریعتر هستند، اما به پرسنل واجد شرایط و تجهیزات گرانقیمت نیاز دارند که فقط در مراکز تخصصی در دسترس هستند. این امر باعث تاخیر در تشخیص می شود که منجر به تجویز و استفاده نادرست از آنتی بیوتیک های وسیع الطیف و در نتیجه ایجاد مقاومت ضد میکروبی می شود. این یکی از بزرگترین مشکلات پزشکی کنونی در زمینه بیماری های عفونی است.
دانشمندان اولین آزمایش تشخیصی آزمایشگاهی را توسعه دادهاند که مولکولهای سیگنالدهنده اصلی سیستم pqs Quorum Sensing (QS)، یکی از مشخصترین سیستمهای ارتباطی P. aeruginosa را شناسایی میکند.
تست میکروپلیت فعلی قوی، دقیق، خاص و بسیار حساس است. هزینه پایینی دارد و امکان تجزیه و تحلیل موازی سریع را فراهم می کند
این آزمایش، که در حال حاضر از نوع ELISA است، میتواند برخی از این مولکولهای سیگنالدهنده را در غلظتهای بسیار پایین (در محدوده nM پایین)، حتی در نمونههای بالینی پیچیده، کمی کند. کمی سازی این مولکول ها می تواند امکان تشخیص زودهنگام عفونت، ارائه اطلاعات در مورد مرحله و تکامل بیماری و همچنین در مورد اثربخشی درمان اعمال شده را فراهم کند. شرکتهای دارویی علاقهمند به همکاری در تجاریسازی این آزمون از طریق قرارداد مجوز ثبت اختراع به دنبال آن هستند.
تست میکروپلیت فعلی قوی، دقیق، خاص و بسیار حساس است. هزینه پایینی دارد و امکان تجزیه و تحلیل موازی سریع و کارآمد نمونه های بالینی متعدد را فراهم می کند. مطالعات بالینی به توانایی این تست در طبقه بندی بیماران بسته به اینکه آیا عفونت P. aeruginosa را در فاز حاد یا مزمن نشان می دهند، اشاره می کند.
این آزمایش را میتوان در پیکربندیهای مختلف، از جمله ریزآرایه، حسگرهای ایمنی و سایر فرمتهای Point of Care (PoC) مانند یک سنجش نواری ساده (LFIA) اجرا کرد. این اجازه می دهد تا آزمایش حتی در مشاوره های مراقبت های اولیه، تشخیص سریع عفونت و استفاده از مناسب ترین درمان ها در مراحل اولیه بیماری انجام شود.





